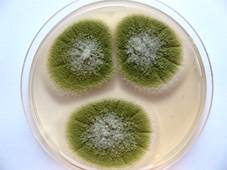

Wyszukiwanie w bazie wiedzy
Zadaniem systemu wentylacyjnego jest utrzymanie odpowiedniej jakości powietrza w całym budynku, określonym pomieszczeniu lub jego części. Najważniejsze parametry powietrza, które można regulować w wentylowanym pomieszczeniu to wartości temperatury, wilgotności, prędkości strugi powietrza oraz stężenia zanieczyszczeń biologicznych i chemicznych.
W miarę wydłużenia się okresu eksploatacji, braku kontroli osiadłego pyłu i mikroorganizmów instalacje wentylacyjne mogą stanowić źródło niepożądanego skażenia powietrza patogennymi drobnoustrojami. Niewłaściwie eksploatowana i konserwowana instalacja wentylacyjna (stosowanie filtrów o zbyt niskiej sprawności, długotrwała eksploatacja filtrów, brak systematycznego czyszczenia lub dezynfekcji) może powodować dodatkową kontaminację pomieszczeń w wyniku wtórnego pylenia.
Warunkiem utrzymania odpowiedniej jakości powietrza w pomieszczeniach jest odpowiednio zaprojektowana, właściwie eksploatowana i konserwowana instalacja wentylacyjna. Istotnym elementem właściwej eksploatacji instalacji wentylacyjnych jest regularna kontrola czystości wentylacji oraz okresowe jej czyszczenie i ewentualnie dezynfekcja.
Szeroki zakres czynności pracowników czyszczących/konserwujących instalacje wentylacyjne, obejmujących ręczne i mechaniczne czyszczenie przewodów wentylacyjnych, czyszczenie parą wodną, mycie i dezynfekcję, uszczelnianie instalacji, przeprowadzany jest na różnego rodzaju obszarze, takim jak domy, biura, obiekty przemysłowe, sklepy wielkopowierzchniowe, szkoły, szpitale itp. Dlatego też należy zwrócić uwagę, że pracownik narażony jest na różnego rodzaju ryzyko, charakterystyczne nie tylko dla czynności jakie wykonuje, ale i dla miejsca, w którym pracuje.


|
TYP ZAGROŻEŃ |
CHARAKTERYSTYKA ZAGROŻEŃ |
|
Czynniki niebezpieczne |
|
|
Zagrożenia chemiczne |
Substancje chemiczne znajdujące się w kurzu, pyle, cząstkach sadzy itp. |
|
Środki stosowane do oczyszczania powierzchni, preparaty biobójcze, czynniki chłodzące z układów chłodniczych |
|
|
Zagrożenia biologiczne |
Szkodliwe czynniki biologiczne występujące w kurzu, obiegach wodnych systemów chłodniczych |
Szkodliwe czynniki biologiczne
Szkodliwe czynniki biologiczne
W instalacjach wentylacyjnych panują zazwyczaj sprzyjające warunki dla rozwoju szkodliwych czynników biologicznych (bakterii i grzybów). Są to przede wszystkim powierzchnie zanieczyszczone cząstkami pyłu, o zwiększonej wilgotności, np.: kanały wentylacyjne, filtry powietrza, izolacje cieplne, tłumiki hałasu, chłodnice powietrza, itp.
|
Na jakie szkodliwe czynniki biologiczne narażeni są pracownicy konserwujący instalacje wentylacyjne podczas wykonywania czynności zawodowych?
Podczas czyszczenia instalacji wentylacyjnych, konserwator może być narażony na chemiczne zanieczyszczenia uwalniane z wyeksploatowanych uszczelek, materiałów doszczelniających i klejów (polimery akrylowe, kauczuk butadienowy, chloroprenowy, butylowy, poli(chlorek winylu), silikon itp.), włókna szklane, fragmenty włóknistych, ognioodpornych wykładzin i materiałów izolacyjnych (w starszych instalacjach klimatyzacyjnych, także włókna azbestu), lotne związki organiczne (LZO) w filtrach powietrza, tłumikach hałasu i materiałach izolacyjnych. Źródłem narażenia pracownika mogą być także środki stosowane do czyszczenia i dezynfekcji instalacji.
Na jakie niebezpieczne czynniki chemiczne narażeni są pracownicy konserwujący instalacje wentylacyjne podczas wykonywania czynności zawodowych?
|